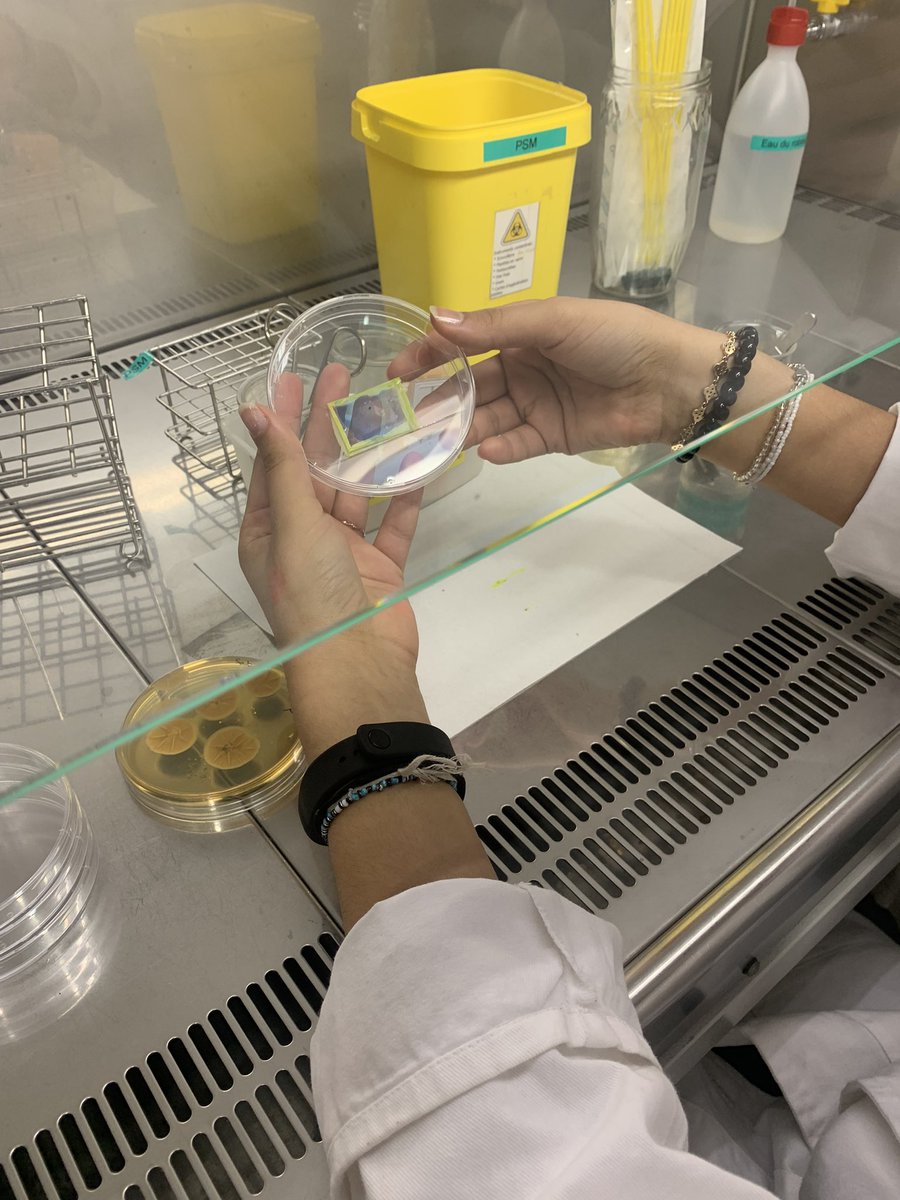
G.Bugarin tweet media

G.Bugarin
126 posts

G.Bugarin
@ProfBugar1
Biotech et pédagogie
Toulouse, France Katılım Aralık 2021
59 Takip Edilen72 Takipçiler


Journée de formation très enrichissante de part des échanges entre collègues et entre prof/chercheur #biotechnologies
Découverte du jeu stem cell therapy … une méthode ludique pour évoquer les enjeux de la #recherche
#sciences #education




Français

Dernier tp pour les deust préparateur en pharmacie… ils sont fin prêts
#biotech #pharmacie #lyceehessel31

Français

Aujourd’hui ! Mini-atelier découverte des #biotech aux collégiens ! on pipette, on microscope, on dose, on précipite …. Pur bonheur pure bonne humeur 🤩#lyceehessel

Français

G.Bugarin retweetledi

#RessourcesUtilesIFE
Vers une marchandisation de l’orientation eduveille.hypotheses.org/17443 via @hypothesesorg par Marie Lauricella
Français
G.Bugarin retweetledi

Le Grand Pasteur à la découverte des petites créatures agar-art.alwaysdata.net/le-grand-paste…
Français
G.Bugarin retweetledi

"La crise sanitaire de #Covid_19 aurait dû mettre en lumière l'importance de la filière technologique dans le domaine des biotechnologies et de la santé. Pourtant, ces filières sont aujourd'hui en déclin en France"
@ValerieRialland
lefigaro.fr/vox/societe/ed…

Français












